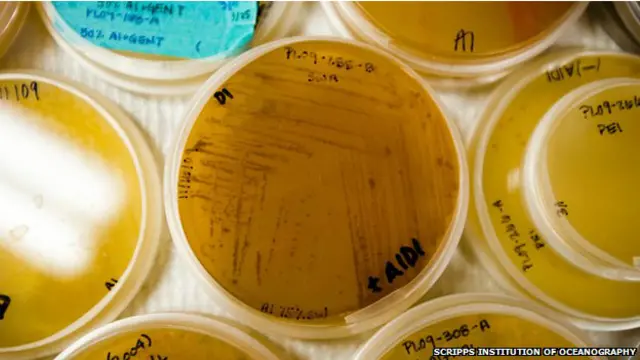
विलक्षण एंटीबॉयोटिक यौगिक

वैज्ञानिकों ने की विलक्षण एंटीबायोटिक की खोज
- Author, साइमन रेडफर्न
- पदनाम, संवाददाता, बीबीसी न्यूज़
अमरीकी वैज्ञानिकों ने कैलिफोर्निया के समुद्र तट की तलहटी में मिले माइक्रोऑर्गैज्म (अति सूक्ष्मजीव) से एक नया विलक्षण एंटीबायोटिक यौगिक प्राप्त किया है.
विशेषज्ञों के अनुसार अब तक अज्ञात रहा यह <link type="page"><caption> एंटीबायोटिक</caption><url href="http://www.bbc.co.uk/hindi/science/2012/12/121229_antibiotic_medicines_vr.shtml" platform="highweb"/></link> विलक्षण है और मानव स्वास्थ्य को गंभीर ख़तरा पहुँचाने वाली दवाइयों के प्रतिरोधक के रूप में काम कर सकता है.
अमरीकी वैज्ञानिकों के अनुसार एंथ्रासिमाइसीन नामक यह नया यौगिक एमआरएसए और <link type="page"><caption> एंथ्रैक्स</caption><url href="http://www.bbc.co.uk/hindi/international/2013/04/130417_ricin_letter_obama_aa.shtml" platform="highweb"/></link> जैसी बीमारियों के इलाज में कारगर हो सकता है. एमआरएसए एक बैक्टीरिया (जीवाणु) है जो संक्रमण वाली कई प्रकार की बीमारियों के लिए ज़िम्मेदार होता है.
इस खोज का विस्तृत विवरण जर्मन शोधपत्र एंगेवैंड्ट केमी में प्रकाशित हुआ है. यह यौगिक जिस स्ट्रेप्टोमाइसेस बैक्टीरिया से निकाला गया है उसे क्रिस्टोफर कॉफ़मैन ने प्रशांत महासागर की तलहटी से प्राप्त किया था.
इस यौगिक की विशिष्ट रासायनिक संरचना नई तरह की एंटीबायोटिक दवाइयों के विकास का मार्ग प्रशस्त कर सकती हैं.
"टाइमबम"
यूएस सेंटर फॉर डिज़ीज़ कंट्रोल एंड प्रिवेंशन के निदेशक थॉमस फ्रीडेन ने हाल ही में एंटीबायोटिक का असर कम करने वाले बैक्टीरिया के बढ़ते ख़तरे से आगाह किया था.
इंग्लैंड के मुख्य चिकित्सा अधिकारी सैली डेवीस ने इस तरह के <link type="page"><caption> बैक्टीरिया</caption><url href="http://www.bbc.co.uk/hindi/science/2013/05/130510_bacteria_against_malaria_rd.shtml" platform="highweb"/></link> की तुलना “’टाइमबम” से करते हुए कहा था कि इस बैक्टीरिया से राष्ट्रीय सुरक्षा को ख़तरा है.

इनफेक्शस डिज़ीज़ सोसाइटी ऑफ अमरीका ने चिंता जताते हुए कहा है कि एंटीबायोटिक के प्रभाव को कम करने वाले बैक्टीरिया की रोकथाम पर पर्याप्त ध्यान नहीं दिया जा रहा है. ऐसी स्थिति में यह नई खोज एक बड़ी खुशख़बरी है.
इस शोधपत्र का प्रकाशन करने वाले कियांग ह्वा जैंग और उनके साथियों ने एंथ्रासिमाइसीन की संरचना का विवरण देते हुए कहा है कि इसकी संरचना पहले से ज्ञात किसी भी प्राकृतिक एंटीबॉयोटिक की संरचना से पूरी तरह भिन्न है.
शोधकर्ताओं की इस टीम के अगुआ विलियम फेनीकल ने कहा, “इस शोध का असली महत्व यह है कि एंथ्रासिमाइसीन की रासायनिक संरचना बिल्कुल ही नई और विशिष्ट है. नए रासायनिक यौगिक की खोज एक विलक्षण परिघटना होती है. इस खोज से इस बात की पुष्टि हुई है कि समुद्र में पाए जाने वाले बैक्टीरिया आनुवंशिक और रासायनिक रूप से विशिष्ट होते हैं.”
इस खोज से इस बात को बल मिला है कि समुद्र में अभी भी ऐसे बहुत से पदार्थ और यौगिक हैं जिनका व्यापक उपयोग हो सकता है.
(बीबीसी हिन्दी के एंड्रॉएड ऐप के लिए आप <link type="page"><caption> यहां क्लिक</caption><url href="http://www.bbc.co.uk/hindi/multimedia/2013/03/130311_bbc_hindi_android_app_pn.shtml" platform="highweb"/></link> कर सकते हैं. आप हमें <link type="page"><caption> फ़ेसबुक</caption><url href="https://www.facebook.com/bbchindi" platform="highweb"/></link> और <link type="page"><caption> ट्विटर</caption><url href="https://twitter.com/BBCHindi" platform="highweb"/></link> पर फ़ॉलो भी कर सकते हैं.)












